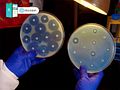

VIETNAMESE
Kháng sinh đồ
Xét nghiệm kháng sinh
ENGLISH
Antibiotic susceptibility test
/ˌæntibaɪˈɒtɪk səˌsɛptɪˈbɪlɪti tɛst/
Drug sensitivity test
“Kháng sinh đồ” là xét nghiệm để xác định độ nhạy cảm của vi khuẩn với kháng sinh.
Ví dụ
1.
Kháng sinh đồ hướng dẫn việc điều trị.
The antibiotic susceptibility test guided treatment.
2.
Cô ấy thực hiện xét nghiệm kháng sinh đồ.
She underwent an antibiotic susceptibility test.
Ghi chú
Từ Kháng sinh đồ là một từ vựng thuộc lĩnh vực y học và vi sinh học. Cùng DOL tìm hiểu thêm về những từ vựng liên quan bên dưới nhé!
 Sensitivity test - Xét nghiệm độ nhạy cảm
Ví dụ: A sensitivity test is performed to determine the most effective antibiotic.
(Xét nghiệm độ nhạy cảm được thực hiện để xác định loại kháng sinh hiệu quả nhất.)
Sensitivity test - Xét nghiệm độ nhạy cảm
Ví dụ: A sensitivity test is performed to determine the most effective antibiotic.
(Xét nghiệm độ nhạy cảm được thực hiện để xác định loại kháng sinh hiệu quả nhất.)
 Antibiotic resistance test - Xét nghiệm kháng kháng sinh
Ví dụ: The antibiotic resistance test helps identify resistant bacteria strains.
(Xét nghiệm kháng kháng sinh giúp xác định các chủng vi khuẩn kháng thuốc.)
Antibiotic resistance test - Xét nghiệm kháng kháng sinh
Ví dụ: The antibiotic resistance test helps identify resistant bacteria strains.
(Xét nghiệm kháng kháng sinh giúp xác định các chủng vi khuẩn kháng thuốc.)
 Culture and sensitivity test - Xét nghiệm cấy và nhạy cảm
Ví dụ: Culture and sensitivity tests are essential for targeted treatment.
(Xét nghiệm cấy và nhạy cảm rất cần thiết để điều trị nhắm mục tiêu.)
Culture and sensitivity test - Xét nghiệm cấy và nhạy cảm
Ví dụ: Culture and sensitivity tests are essential for targeted treatment.
(Xét nghiệm cấy và nhạy cảm rất cần thiết để điều trị nhắm mục tiêu.)
Danh sách từ mới nhất:
Xem chi tiết



